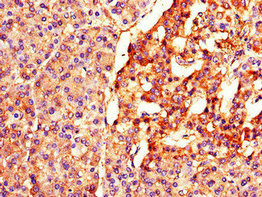

-
中文名稱:BTRC兔多克隆抗體
-
貨號:CSB-PA897464LA01HU
-
規格:¥440
-
圖片:
-
其他:
產品詳情
-
產品名稱:Rabbit anti-Homo sapiens (Human) BTRC Polyclonal antibody
-
Uniprot No.:
-
基因名:
-
別名:Beta transducin repeat containing E3 ubiquitin protein ligase antibody; beta TrCP1 antibody; beta-transducin repeat containing antibody; BETA-TRCP antibody; betaTrCP antibody; btrC antibody; bTrCP antibody; bTrCP1 antibody; E3RSIkappaB antibody; F box and WD repeat protein 1B antibody; F box and WD repeats protein beta TrCP antibody; F-box and WD repeats protein beta-TrCP antibody; F-box/WD repeat protein 1A antibody; F-box/WD repeat-containing protein 1A antibody; FBW1A antibody; FBW1A_HUMAN antibody; FBXW1 antibody; FBXW1A antibody; FWD1 antibody; HOS antibody; mKIAA4123 antibody; pIkappaBalpha-E3 receptor subunit antibody; Slimb antibody
-
宿主:Rabbit
-
反應種屬:Human
-
免疫原:Recombinant Human F-box/WD repeat-containing protein 1A protein (397-448AA)
-
免疫原種屬:Homo sapiens (Human)
-
標記方式:Non-conjugated
本頁面中的產品,BTRC Antibody (CSB-PA897464LA01HU),的標記方式是Non-conjugated。對于BTRC Antibody,我們還提供其他標記。見下表:
-
克隆類型:Polyclonal
-
抗體亞型:IgG
-
純化方式:>95%, Protein G purified
-
濃度:It differs from different batches. Please contact us to confirm it.
-
保存緩沖液:Preservative: 0.03% Proclin 300
Constituents: 50% Glycerol, 0.01M PBS, PH 7.4 -
產品提供形式:Liquid
-
應用范圍:ELISA, IHC, IF
-
推薦稀釋比:
Application Recommended Dilution IHC 1:20-1:200 IF 1:50-1:200 -
Protocols:
-
儲存條件:Upon receipt, store at -20°C or -80°C. Avoid repeated freeze.
-
貨期:Basically, we can dispatch the products out in 1-3 working days after receiving your orders. Delivery time maybe differs from different purchasing way or location, please kindly consult your local distributors for specific delivery time.
-
用途:For Research Use Only. Not for use in diagnostic or therapeutic procedures.
引用文獻
- βTrCP1 promotes SLC35F2 protein ubiquitination and inhibits cancer progression in HeLa cells JC Colaco,Biochemical and biophysical research communications,2023
相關產品
靶點詳情
-
功能:Substrate recognition component of a SCF (SKP1-CUL1-F-box protein) E3 ubiquitin-protein ligase complex which mediates the ubiquitination and subsequent proteasomal degradation of target proteins. Recognizes and binds to phosphorylated target proteins. SCF(BTRC) mediates the ubiquitination of CTNNB1 and participates in Wnt signaling. SCF(BTRC) mediates the ubiquitination of phosphorylated NFKB1, ATF4, CDC25A, DLG1, FBXO5, PER1, SMAD3, SMAD4, SNAI1 and probably NFKB2. SCF(BTRC) mediates the ubiquitination of NFKBIA, NFKBIB and NFKBIE; the degradation frees the associated NFKB1 to translocate into the nucleus and to activate transcription. Ubiquitination of NFKBIA occurs at 'Lys-21' and 'Lys-22'. SCF(BTRC) mediates the ubiquitination of CEP68; this is required for centriole separation during mitosis. SCF(BTRC) mediates the ubiquitination and subsequent degradation of nuclear NFE2L1. Has an essential role in the control of the clock-dependent transcription via degradation of phosphorylated PER1 and PER2. May be involved in ubiquitination and subsequent proteasomal degradation through a DBB1-CUL4 E3 ubiquitin-protein ligase. Required for activation of NFKB-mediated transcription by IL1B, MAP3K14, MAP3K1, IKBKB and TNF. Required for proteolytic processing of GLI3. Mediates ubiquitination of REST, thereby leading to its proteasomal degradation. SCF(BTRC) mediates the ubiquitination and subsequent proteasomal degradation of KLF4; thereby negatively regulating cell pluripotency maintenance and embryogenesis.
-
基因功能參考文獻:
- The primary role of the S(52,56) residues of Vpu in antagonism of CD4, GaLV Env, and BST-2/tetherin is to recruit the SCF/betaTrCP ubiquitin ligase. PMID: 30347660
- TSPAN15 interacts with BTRC to promote oesophageal squamous cell carcinoma metastasis via activating NF-kappaB signaling. PMID: 29650964
- BTrCP-FBXW2-SKP2 axis forms an oncogene-tumour suppressor-oncogene cascade to control cancer cell growth with FBXW2 acting as a tumour suppressor by promoting SKP2 degradation. PMID: 28090088
- Data show that the SCF(beta-TrCP) ubiquitin E3 ligase complex responsible for regulating the active protein kinase C-associated kinase (RIPK4) level. PMID: 29435596
- SAG/RBX2 E3 ligase complexes with UBCH10 and UBE2S ubiquitin-conjugating enzymes to ubiquitylate beta-TrCP1 via K11-linkage for degradation. PMID: 27910872
- Data indicate the role of tyrosine kinase c-Src (Src) in rescuing Taz (transcriptional coactivator with PDZ-binding motif) from E3 ligase SCF(beta-TrCP)-mediated degradation. PMID: 28154141
- SCFbeta-TRCP negatively regulates the FLCN complex by promoting FNIP2 degradation in Birt-Hogg-Dube syndrome-associated renal cancer. PMID: 28039480
- beta-TRCP depletion in HepG2 hepatocellular carcinoma cells resulted in increased Lipin1 protein abundance. PMID: 28049764
- It demonstrates that degradation of Lipin-1 is regulated by BTRC in the cytoplasm and on membranes PMID: 28483528
- It has been proposed that CENP-W may function as a booster of beta-TrCP1 nuclear import to increase the oncogenicity of beta-TrCP1. PMID: 27861801
- oncogenic effect of miR-182 and its reversal by beta-TrCP2 were confirmed in vivo This study suggests that beta-TrCP and miR-182 may be possible biomarkers and targets for early detection and treatment of pancreatic cancer PMID: 27797718
- Beta-TrCP controls ubiquitination and degradation of liver-enriched transcription factor CREB-H. PMID: 27029215
- Phosphorylated VEGFR-2 was reduced by hyperglycemia while total VEGFR-2 was almost unaltered. However, VEGFR-2 was reduced when directly exposed to reactive oxygen species, with resultant co-location of beta-TrCP and VEGFR-2. PMID: 26935904
- EBV-miR-BART10-3p facilitated epithelial-mesenchymal transition and promotes metastasis of nasopharyngeal carcinoma by targeting BTRC. PMID: 26497204
- beta-TrCP1/FWD1 dominant negative mutant has a role in reducing myeloma cell growth PMID: 26009993
- This study showed SCF(beta-TRCP) earmarks Set8 for ubiquitination and degradation in a casein kinase I-dependent manner, which is activated by DNA-damaging agents. PMID: 26666832
- SCF(beta-TrCP1/2) interacting partners, were identified. PMID: 25900982
- a model that CD166 regulates MCAM through a signaling flow from activation of PI3K/AKT and c-Raf/MEK/ERK signaling to the inhibition of potential MCAM ubiquitin E3 ligases, betaTrCP and Smurf1. PMID: 26004137
- Human rotavirus NSP1 functions by mimicking the host IkappaB phosphodegron recognized by beta-TrCP. PMID: 25626907
- Interaction between the phosphorylated degron motif of TRIM9 and the WD40 repeat region of beta-TrCP prevented beta-TrCP from binding its substrates, stabilizing IkappaBalpha and p100 and thereby blocking NF-kappaB activation. PMID: 25190485
- These results show that human rotaviruses commonly inhibit the NF-kappaB pathway via their NSP1 protein by degrading beta-TrCP and thus stabilizing IkappaB. PMID: 25701827
- No evidence of a direct association between beta-TRCP polymorphisms and breast cancer. PMID: 26003292
- identified 221 proteins that contained the DpSGXX(X)pS motif and also interacted specifically with the WD40 repeats of betaTrCP. PMID: 25515538
- beta-TrCP has an important role in controlling H3K27 trimethylation activity and lymphoma pathogenesis by targeting EZH2 for degradation. PMID: 24469040
- TRIB2 associated-ubiquitin E3 ligases beta-transducin repeat-containing E3 ubiquitin protein ligase (beta-TrCP), COP1 and Smad ubiquitination regulatory factor 1 (Smurf1) reduced TCF4/beta-Catenin expression, and these effects could be enhanced by TRIB2. PMID: 25311538
- NORE1A has a role in Ras regulation of SCF(beta-TrCP) protein activity and specificity PMID: 25217643
- Study provides a novel molecular mechanism for the negative regulation of MTSS1 by beta-TRCP in cancer cells. PMID: 24318128
- Upon DNA-damaging anticancer drug treatment, CK1/beta-TrCP-mediated Tiam1 degradation is abolished, and the accumulated Tiam1 contributes to downstream activation of Rac1/JNK. PMID: 24737324
- Wnt stimulation induced prolonged monoubiquitination of Gsk3beta and Gsk3beta-beta-TrCP interaction. PMID: 24451375
- betaTrCP-dependent degradation of TFAP4 is required for the fidelity of mitotic division PMID: 24500709
- this study showed betaTrCP-mediated regulation of Mis18beta stability is a mechanism to restrict centromere function of Mis18 complex from late mitosis to early G1 phase. PMID: 24269809
- we found no evidence of association between the 9N ins/del polymorphism of the b-TrCP gene and EOC in this Chinese population PMID: 23546975
- SIRT1 acts as a negative regulator of beta-TrCP synthesis via promoting protein degradation. PMID: 24211209
- a model in which TNFalpha-induced beta-TrCP1 accumulation promotes SMRT degradation and the subsequent induction of proinflammatory gene expression. PMID: 23861398
- suggest that interaction of S100A4 and Rhotekin permits S100A4 to complex with RhoA and switch Rho function from stress fiber formation to membrane ruffling to confer an invasive phenotype PMID: 22964642
- SGT1 could enhance the binding between PHLPP1 and beta-TrCP which has been documented to be able to target PHLPP1 for destruction PMID: 23440515
- Results indicate that beta-TrCP1 is involved in the negative regulation of TRF1. PMID: 23583392
- Hsp27 and F-box protein beta-TrCP promote degradation of mRNA decay factor AUF1. PMID: 23530064
- mutational analysis indicates that IKKalpha-dependent phosphorylation at Ser-304 is crucial to the binding of HuR to beta-TrCP1. PMID: 23115237
- Knockdown of beta-TrCP1 and beta-TrCP2 attenuated the K48-linked ubiquitination and degradation of IRAK1. PMID: 22851693
- Fas-associated factor 1 is a scaffold protein that promotes beta-transducin repeat-containing protein (beta-TrCP)-mediated beta-catenin ubiquitination and degradation. PMID: 22730322
- Identified are three arginine residues of beta TrCP that participate in NRF2 docking. PMID: 22751928
- phosphorylated TAZ binds to the beta-TrCP subunit of the SCF(beta-TrCP) E3 ubiquitin ligase PMID: 22692215
- Data show that beta-TRCP knockdown causes accumulation of VEGFR2, resulting in increased activity of signaling pathways downstream of VEGFR2. PMID: 22711876
- this review discusses beta-TrCP's new downstream substrate, DEPTOR, as well as summarize the novel functional aspects of beta-TrCP in controlling cell growth and regulating autophagy, in part through governing the stability of DEPTOR.[Review] PMID: 22454292
- IL-10R1 is a novel substrate of betaTrCP-containing ubiquitin E3 ligase, a novel negative regulatory mechanism that may potentially affect IL-10 function PMID: 22087322
- Data indicate that knockdown of beta-TrCP1 and beta-TrCP2 markedly reduced IL-17-induced, phosphorylation-dependent ubiquitination and degradation of Act1. PMID: 22045853
- mTOR drives its own activation via SCF(betaTrCP)-dependent degradation of the mTOR inhibitor DEP PMID: 22017875
- Endogenous DEPTOR levels are negatively regulated by betaTrCP. PMID: 22017876
- mTOR generates an auto-amplification loop by triggering the betaTrCP- and CK1alpha-dependent degradation of DEPTOR PMID: 22017877
顯示更多
收起更多
-
亞細胞定位:Cytoplasm. Nucleus.
-
組織特異性:Expressed in epididymis (at protein level).
-
數據庫鏈接:
Most popular with customers
-
-
YWHAB Recombinant Monoclonal Antibody
Applications: ELISA, WB, IHC, IF, FC
Species Reactivity: Human, Mouse, Rat
-
Phospho-YAP1 (S127) Recombinant Monoclonal Antibody
Applications: ELISA, WB, IHC
Species Reactivity: Human
-
-
-
-
-